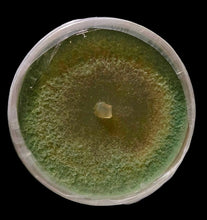
Load image into Gallery viewer, Trichoderma afroharzianum T22 culture
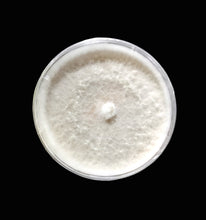
Load image into Gallery viewer, Trichoderma afroharzianum T22 culture

Trichoderma afroharzianum T22 (formerly T. harzianum T22)
Description:
Trichoderma afroharzianum T22 is a globally recognized strain, originally described as T. harzianum, with decades of validation as both a plant biocontrol organism and a biotechnology workhorse. T22’s broad-spectrum enzymatic activity has made it one of the most versatile Trichoderma strains available.
Package Includes:
1 × Verified culture on 100 mm CellTreat Grip ring petri dish. Usually on PDA or V8.
1 × Slant for medium-term refrigerated storage. Usually on PDA or V8.
Backup Guarantee: Valid for 2 years. Buyer may request 1 replacement slant in case of culture loss (nominal processing + shipping fee).
Potent Lysing Agent:
Produces high levels of cell wall degrading enzymes, including chitinases, β-glucanases, cellulases, and proteases.
Efficient for lysing fungal, oomycete, and even some bacterial and algal cells.
Useful for DNA/RNA extraction prep, metabolite release, enzyme screening, and bioprocessing workflows.
Biocontrol Efficacy:
Strong antagonism against Fusarium, Pythium, Rhizoctonia, Sclerotinia, and other soilborne pathogens.
Induces systemic resistance in plants, boosting natural defenses and abiotic stress tolerance.
Commercial Provenance:
One of the most widely studied and deployed Trichoderma strains worldwide.
Extensively documented in academic, industrial, and agricultural research.
Reclassified taxonomically from T. harzianum → T. afroharzianum but retains the same lineage and proven track record. For decades, Trichoderma harzianum was treated as a single “catch-all” species that included many morphologically similar but genetically distinct lineages. It became a species complex: dozens of strains, isolated worldwide, were all lumped together because their spores and colonies looked alike.
With the advent of molecular biology and phylogenetics (multi-locus sequencing and later whole genome):
Researchers sequenced ITS, tef1-α, rpb2, and other genetic markers.
Phylogenetic trees showed that what was once called T. harzianum actually split into several well-supported clades (cryptic species).
T22 clustered consistently within a distinct African lineage, later formally described as Trichoderma afroharzianum.
This reclassification was confirmed by genome-wide comparisons, which showed enough divergence from the “true” harzianum clade to justify a separate species.
Applications:
Lab and Biotech: Cell lysis/protoplasts, enzyme production, metabolite recovery, genetic material extraction.
Agriculture: Seed treatment, soil inoculant, root colonizer, and pathogen suppressor.
R&D: Platform strain for studying Trichoderma genetics, enzyme discovery, and biocontrol mechanisms.
🧫 Culturing Information
General media: PDA (Potato Dextrose Agar DSMZ 129. I prefer buying dehydrated PD broth powder and mixing 10-20g with 15-18g agar and 1000mL H2O), MEA (Malt Extract Agar DSMZ 90), or CMA (Cornmeal Agar DSMZ 191) support rapid growth.
High nutrient media: V8 agar (V8 juice agar DSMZ 310), regeneration media, and other enriched formulas as well as liquid culturing significantly delay sporulation or in the case of liquid culture as long as the culture is fully submerged sporulation can be delayed indefinitely, maintaining cultures to delay sporulating can be desirable to reduce the risk of cross contamination when working with other non Trichoderma cultures in the same work space since Trichoderma eats other fungi.
Temperature range: Best growth at 25-28 °C; viable across 15-30 °C.
Colony morphology: Fast growing white mycelium, transitioning to green sporulation in 3-5 days on standard media. Sporulation timing varies by nutrient availability, V8 agar and regeneration media can often delay sporulation by an additional week or more.
Subculturing: Transfer every 2-4 weeks
Storage:
Refrigerated slants at 4-8 °C: stable 12-36 months
Long term: cryopreservation or lyophilization
Disclaimer:
For research and educational use only.
Not registered as a commercial pesticide or formulation.
End users are responsible for ensuring compliance with local regulations.